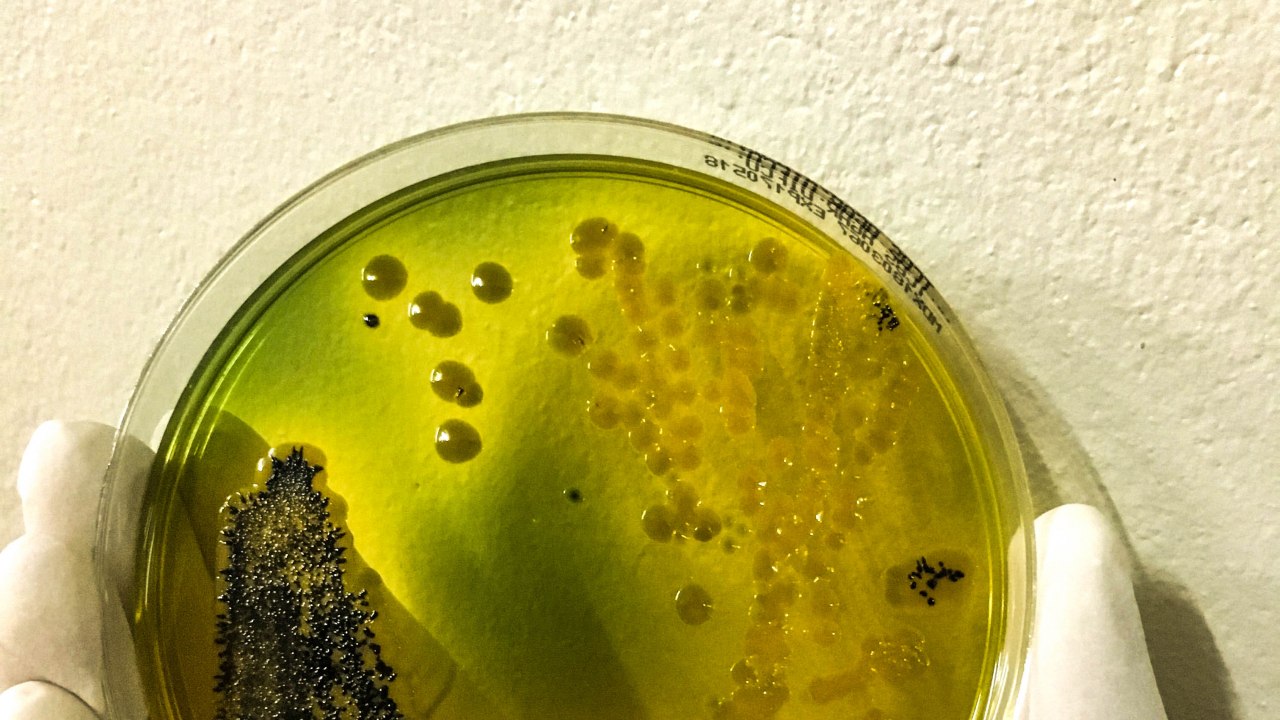

Koristite zastareli preglednik. Možda se neće pravilno prikazivati ova ili druge veb stranice.
Trebalo bi da nadogradite ili koristite alternativni preglednik.
Trebalo bi da nadogradite ili koristite alternativni preglednik.
Epidemija CoViD-19
- Začetnik teme Zuma
- Datum pokretanja
Пантограф
Professional
- Učlanjen(a)
- 23.04.2012.
- Poruke
- 21.561
- Pohvaljen
- 49.694
Mistake to Recommend COVID-19 Vaccines for All Children: Top Danish Health Official
“I want to look all parents of children who have vaccinated their child in the eye and say, ‘You did the right thing and thank you for listening,'” Brostrøm said.
“But at the same time—and this is the important thing to maintain confidence—I will admit and say that we have become wiser and we would not do the same today. And we will not do that in the future either,” he added.
...
He said the country did well amid the pandemic in the winter of 2021 even though it removed restrictions due to vaccination. “The strategy for the coming winter is also that the vaccines should get us through a new wave without restriction,” he said in a statement.
“I want to look all parents of children who have vaccinated their child in the eye and say, ‘You did the right thing and thank you for listening,'” Brostrøm said.
“But at the same time—and this is the important thing to maintain confidence—I will admit and say that we have become wiser and we would not do the same today. And we will not do that in the future either,” he added.
...
He said the country did well amid the pandemic in the winter of 2021 even though it removed restrictions due to vaccination. “The strategy for the coming winter is also that the vaccines should get us through a new wave without restriction,” he said in a statement.
Bender Rodriguez
Professional
- Učlanjen(a)
- 12.03.2017.
- Poruke
- 27.714
- Pohvaljen
- 64.798
Ne samo maske nego i gumene skafandere i rukavice pod obavezno na ovih 40 stepeni.
A valjalo bi razmisliti i o policijskom casu, cuo sam da je to mnogo dobro ne samo za zdravlje nego i za ekonomiju.
A valjalo bi razmisliti i o policijskom casu, cuo sam da je to mnogo dobro ne samo za zdravlje nego i za ekonomiju.
Poslednja izmena:
astrodule
Professional
Broj umrlih ne raste, tako da nema potrebe ni za kakvim novim merama.
Dzigi Bau
Advanced
- Učlanjen(a)
- 25.05.2018.
- Poruke
- 4.907
- Pohvaljen
- 12.413
Ако мислиш да ће маска да ти могне носи је ко ти брани, надам се да су се људи опаметили и да неће насести опет, да видим тог јунака који ће да покуша опет да уводи полицијски час и маске на 40 степени,Broj obolelih i umrlih sve vise raste.
Treba li uvesti obavezu nosenja maski?
кад се само сетим свих идиотизам као на пример да пензионери могу да излазе из куће само од 4 до 7 ујутру недељом или кад је АБХО прао улице или малтене укидање ГСП-а и слично.
Ti svi idiotizmi su idiotizmi sada, ali u situaciji kada nije postojala vakcina, pa je virus odnosio svakog petog seniora, i kada smo izgubili preko 200 zdravstvenih radnika, ja ih ne bih sve tako kvalifikovao. Sada i ubuduće, bez sumnje, bih,
Bender Rodriguez
Professional
- Učlanjen(a)
- 12.03.2017.
- Poruke
- 27.714
- Pohvaljen
- 64.798
Jedini period kada su policijski cas i zatvaranja bili opravdani jeste april 2020. Dok se jos nije znalo s kakvom vestackom abominacijom imamo posla. Cim je postalo jasno da virus ipak nece okoncati svet, da nece pobiti cak ni 1%, trebalo je obustaviti zatvaranja.
Ta jbna kineska abominacija i sve mere oko nje, od najstrozih do nekih naizgled trivijalnih, su ceo svet kostali ekonomije.
Nema svet luksuz vise da misli o Koroni. Nije imao ni leta 2020. a tek nema sada. Gotovo je, cirkus je zavrsen. Izrodise se novi problemi i krize (da ne znam bolje pomislio bih da se planeta namerno drzi u krizama vec 15 godina). Treba spasavati ekonomiju, hranu i energetiku. Kome je i dalje do igranja sa Koronom, bilo u vidu maski bilo u vidu brojki, slobodno nek se igra, al za svoj gros. Vecinu ostalih Korona vise prosto ne zanima. Treba pregrmeti ovu zimu i ove krizetine koje nam namestise (nama, obicnim ljudima sirom sveta).
Masku cu ponovo nositi samo kada budem sumnjao da sam mozda prehladjen ili da opet imam Koronu a moram u prevoz ili u javne objekte. Inace van toga, nikad vise. Dosta je, vreme je da se zatvori to poglavlje cirkusa, posto smo u medjuvremenu otvorili nekoliko novih.
Ta jbna kineska abominacija i sve mere oko nje, od najstrozih do nekih naizgled trivijalnih, su ceo svet kostali ekonomije.
Nema svet luksuz vise da misli o Koroni. Nije imao ni leta 2020. a tek nema sada. Gotovo je, cirkus je zavrsen. Izrodise se novi problemi i krize (da ne znam bolje pomislio bih da se planeta namerno drzi u krizama vec 15 godina). Treba spasavati ekonomiju, hranu i energetiku. Kome je i dalje do igranja sa Koronom, bilo u vidu maski bilo u vidu brojki, slobodno nek se igra, al za svoj gros. Vecinu ostalih Korona vise prosto ne zanima. Treba pregrmeti ovu zimu i ove krizetine koje nam namestise (nama, obicnim ljudima sirom sveta).
Masku cu ponovo nositi samo kada budem sumnjao da sam mozda prehladjen ili da opet imam Koronu a moram u prevoz ili u javne objekte. Inace van toga, nikad vise. Dosta je, vreme je da se zatvori to poglavlje cirkusa, posto smo u medjuvremenu otvorili nekoliko novih.
Poslednja izmena:
Bender Rodriguez
Professional
- Učlanjen(a)
- 12.03.2017.
- Poruke
- 27.714
- Pohvaljen
- 64.798
Juče u polupraznom Higeru na Autokomandi neki sredovečni paničar sa maskom preko lica odjednom počne da apeluje na putnike da pootvaraju prozore jer ''ne radi klima''. A klima naravno radi, ne jako ali dovoljno da bude podnošljivo, pogotovu kad je svežiji letnji dan. Ali jbg, kad staviš brnjicu preko usta i nosa i dišeš u nju, i kada paničiš na sve, naravno da će da ti bude toplo. Doduše čini mi se da čovek nije baš bio skroz sam sa sobom ali ne bih znao, jer nisam posle ni obraćao pažnju. Kapiram da nije njemu bilo toliko vruće koliko se us**o klima uređaja.
Bender Rodriguez
Professional
- Učlanjen(a)
- 12.03.2017.
- Poruke
- 27.714
- Pohvaljen
- 64.798
O ne, samo ne 5.2.1...
Dzigi Bau
Advanced
- Učlanjen(a)
- 25.05.2018.
- Poruke
- 4.907
- Pohvaljen
- 12.413
Какав је тај шта кажу, јел помаже против њега 5.доза ФајзераOtkriven je slučaj koronavirusa koji uključuje novi soj omikrona BA.5.2.1.
astrodule
Professional
Meni se čini da je nošenje maske malo oslabilo imunitet ljudi (to mi deluje logično), ali kako to dokazati i pokazati da nije zbog vakcina, a možda i jeste...
Bender Rodriguez
Professional
- Učlanjen(a)
- 12.03.2017.
- Poruke
- 27.714
- Pohvaljen
- 64.798
Kačim zbog ove video-ankete sa početka klipa.
U anketi, 3/4 ljudi više ne zanima ili prate osnovne informacije čisto iz predostrožnosti, da ne bi fasovali pa da budu prikovani za krevet i kuću dok se oporave. Ostalih 1/4 čine paničari i/ili hronični bolesnici i/ili stariji, koji mogu da budu u realnoj opasnosti od Kovida i za njih je razumljivo da se paze, samo dok ne mrače ostatak društva da stoji paralisano zbog toga.
U suštini, postao je nešto nalik gripu i to je to. Svet nije nestao, virus nije pobio čovečanstvo. Ali može da nestane svetska ekonomija ako se u jeku ovih krizetina i enormnih zaduženja i nestašica, ponovo sve pozatvara ili osakati novim merama i histerijama.
U anketi, 3/4 ljudi više ne zanima ili prate osnovne informacije čisto iz predostrožnosti, da ne bi fasovali pa da budu prikovani za krevet i kuću dok se oporave. Ostalih 1/4 čine paničari i/ili hronični bolesnici i/ili stariji, koji mogu da budu u realnoj opasnosti od Kovida i za njih je razumljivo da se paze, samo dok ne mrače ostatak društva da stoji paralisano zbog toga.
U suštini, postao je nešto nalik gripu i to je to. Svet nije nestao, virus nije pobio čovečanstvo. Ali može da nestane svetska ekonomija ako se u jeku ovih krizetina i enormnih zaduženja i nestašica, ponovo sve pozatvara ili osakati novim merama i histerijama.
Bender Rodriguez
Professional
- Učlanjen(a)
- 12.03.2017.
- Poruke
- 27.714
- Pohvaljen
- 64.798
Нови сојеви нису опасни, корона постаје као грип
Епидемиолошка ситуација у Србији је стабилна, а корона вирус на издисају, упркос томе што, због мутација, има све више заражених, будући да нове варијације ковида не дају тежу клиничку слику, каже инфектолог Дарко Ножић. „Због мутација вируса више нема имунитета, тако да се сваким даном све више људи заражује. На срећу, ти сојеви, БА 4 и БА 5, који су сада код нас, не дају тежу клиничку слику. Далеко је тежа ситуација била када је био делта сој”, рекао је Ножић за Танјуг. Како каже, вирус сада има велику заразност, брзо се преноси, али, за сада, без неких већих последица. Ножић појашњава да су симптоми БА 4 и БА 5 сојева уобичајени за респираторне инфекције - главобоља, повишена температура, цурење из носа, кашаљ, а могу да буду и болови у мишићима и стомачне тегобе. На питање о новом соју Кентаур, који се појавио у неким деловима света, Ножић одговара - „кога је змија ујела и гуштера се плаши”. Он истиче да су још свеже ране пандемије ковида 19, те да је за две године умрло много људи и да, самим тим, појава нечег новог изазива зазор.„Међутим, вирус ипак иде ка својој пацификацији. Појављују се нови сојеви који су заразни, али мала је вероватноћа да он може да се за кратко време реконструише тако да изазива теже клиничке слике”, рекао је Ножић и додао да верује да Кентаур неће донети веће проблеме. Према његовом мишљењу, пандемија коронавируса приводи се крају. „То је вирус са којим ћемо морати да живимо. Чак не знам колико је уопште потребно тестирање. И за грип постоје тестови, али мало ко се одлучи за њега. У овом тренутку, корона није тежа болест од грипа”, закључио је Ножић.

Нови сојеви нису опасни, корона постаје као грип
Епидемиолошка ситуација у Србији је стабилна, а корона вирус на издисају, упркос томе што, због мутација, има све више заражених, будући да нове варијације ковида не дају тежу клиничку слику, каже инфектолог Дарко Ножић. „Због мутација вируса више нема имунитета, тако да се сваким даном све више...
Ne znam koliko su opasni ali mi je (opet) sve po spisku. Ovo je prvi put da sam zvanično dobio koronu. I sa temperaturom ispod 38 se osećam kao da me u kontinutetu gazi teretni voz.
Ispred kovid ambulante za Zvezdaru je bilo 50tak ljudi, čekao 4+ sata.
Ispred kovid ambulante za Zvezdaru je bilo 50tak ljudi, čekao 4+ sata.
Želim da verujem da će virus oslabiti i da će biti kao prehlada. A onda se setim moje rođake koja je preminula od delta soja, onda moje sestra koja je bila 3 nedelje u bolnici, pa mog kuma koji je bio u Batajnici i jedva se izvukao, pa jednog prijatelja koji još uvek ima ožiljke na plućima i koji se jedva penje stepenicama....
I onda me moja opuštenost brzo napusti
I onda me moja opuštenost brzo napusti
Bender Rodriguez
Professional
- Učlanjen(a)
- 12.03.2017.
- Poruke
- 27.714
- Pohvaljen
- 64.798
Ovi debili nikad neće naučiti...
Nakon što su kineske vlasti u ponedeljak saopštile da je jedan student u Vuhanu zaražen kolerom, sinoć je objavljeno da je isti soj bakterije koja izaziva tu zaraznu bolest pronađen i kod kornjače na pijaci, objavio je Rojters.

 www.b92.net
www.b92.net
Panika u Vuhanu, nova zaraza sa pijace, student ima koleru: "Hitno pronađite izvor"
Nakon što su kineske vlasti u ponedeljak saopštile da je jedan student u Vuhanu zaražen kolerom, sinoć je objavljeno da je isti soj bakterije koja izaziva tu zaraznu bolest pronađen i kod kornjače na pijaci, objavio je Rojters.

Panika u Vuhanu, nova zaraza sa pijace, student ima koleru: "Hitno pronađite izvor"
Nakon što su kineske vlasti u ponedeljak saopštile da je jedan student u Vuhanu zaražen kolerom, sinoć je objavljeno da je isti soj bakterije koja izaziva tu zaraznu bolest pronađen i kod kornjače na pijaci, objavio je Rojters.
Nije samo Kina, i nije Kina najgora. Modernizovani gradovi u Kini čak imaju nekakvu vodovodnu i kanalizacionu mrežu. Kineska provincija, Indija, Bangladeš, Indonezija su neuporedivo gori.Ovi debili nikad neće naučiti...
Panika u Vuhanu, nova zaraza sa pijace, student ima koleru: "Hitno pronađite izvor"
Nakon što su kineske vlasti u ponedeljak saopštile da je jedan student u Vuhanu zaražen kolerom, sinoć je objavljeno da je isti soj bakterije koja izaziva tu zaraznu bolest pronađen i kod kornjače na pijaci, objavio je Rojters.
Panika u Vuhanu, nova zaraza sa pijace, student ima koleru: "Hitno pronađite izvor"
Nakon što su kineske vlasti u ponedeljak saopštile da je jedan student u Vuhanu zaražen kolerom, sinoć je objavljeno da je isti soj bakterije koja izaziva tu zaraznu bolest pronađen i kod kornjače na pijaci, objavio je Rojters.www.b92.net
Jako velike koncentracija ljudi i domaćih životinja, loši sanitarni uslovi. Idealan recept za nove bolesti i epidemije od kako postoje urbane sredine i stočarstvo.
Preporučite:

